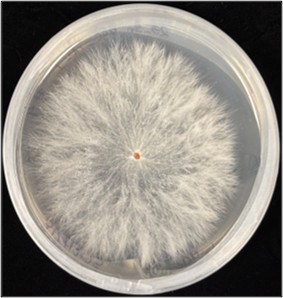

Research Projects
Sustainable Rose Project



Our collaborative USDA SCRI-funded Sustainable Rose Project is a multi-state project aimed at developing sustainable rose landscapes through Rose Rosette Disease (RRD) education and breeding RRD resistant roses with stable black spot resistance. RRD is caused by rose rosette virus (RRV), is a widespread threat in the USA to rose producers, landscapers, and consumers. RRD has been destroying thousands of roses in landscapes, private/public gardens and wholesale/retail nurseries. RRV spreads from infected to healthy plants via the eriophyid mite Phyllocoptes frucitphilus (pf). Once the virus infects the roses, the plant dies within weeks to a few years. Therefore, finding host resistant against virus and mite is crucial for RRD management. For more information visit: roserosette.org.
At UT Plateau Ag-Research and Education Center in Crossville, TN, we are screening thousands of rose cultivars to identify those resistant to rose rosette virus. In Addition to studying the RRV-host interaction on rose cultivars, we are conducting a specific field study to characterize the interaction of mite (Pf) with different rose cultivars.
Some goals of the project:
- To characterize the RRV-host interaction in rose cultivars
- To characterize the mite-host interaction in rose cultivars
- To identify effective miticides and antiviral compound combinations in reducing mite populations in the field
Molecular characterization of Southern blight pathogen on ornamental plants
Southern blight is an increasingly important disease affecting a wide range of ornamental plants in nurseries and landscapes. In recent years, we have observed significant variability in disease severity and host range. This project focuses on the morphological and molecular characterization of different isolates of the southern blight pathogen, Agrothelia rosflii, collected from ornamental hosts. Our goal is to better understand how isolates differ in colony characterization, growth, and their genetic diversity.
By combing traditional morphology-based identification with molecular tools, we aim to understand the pathogen diversity that ultimately support the development of effective disease management strategies for the nursery industry. This work contributes to improving diagnostic accuracy, guiding chemical and cultural control methods and strengthening long-term disease management programs for ornamental crops.

Extension Projects


Our collaborative USDA SCRI-funded project aims to develop research demonstrations and educational programs for the management of rose rosette disease (RRD). The Research and Extension demonstration of the RRD trial is accessible to the public, allowing them to observe disease symptoms and learn more about rose rosette and black spot diseases. Currently, the public can participate in disease rating at the UT Plateau Ag-Research and Education Center, Crossville, TN. Visit the demonstration plots, scan the QR code, and follow the direction to participate in research.

